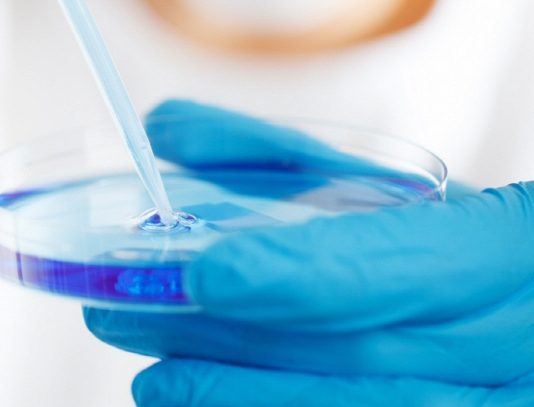

40헤르츠(Hz) 주파수의 빛과 소리 자극이 알츠하이머 퇴치에 도움이 될 수 있다는 연구 결과가 발표됐다. 이 연구는 쥐를 대상으로 진행되었지만, 인간에게도 긍정적인 영향을 미칠 가능성을 제시하며 알츠하이머 치료에 새로운 희망을 가져다주고 있다.매사추세츠공과대학(MIT) 연구진은 최근 논문(Multisensory gamma stimulation promotes glymphatic clearance of amyloid, 네이처)에서 40Hz 자극이 알츠하이머 환자의 뇌에서 베타 아밀로이드...
인후암 수술이나 성대 폴립 등의 영향으로 성대를 사용할 수 없게 된 사람도 근육의 움직임을 말소리로 바꿔주는 '목에 붙이는 패치'가 캘리포니아대학교 로스앤젤레스 캠퍼스 연구팀에 의해 개발됐다. 연구 결과(논문명: Speaking without vocal folds using a machine-learning-assisted wearable sensing-actuation system)는 네이처 커뮤니케이션즈(Nature Communications)에 3월 12일(현지시각) 실렸다.이 패치는 작고 신축성이 있으며, 발화에 따른 근육의...
13m 높이의 거대한 '모래전지'로 풍력, 태양광 발전의 잉여 에너지를 열로 저장하는 프로젝트가 진행 중이다.지구 온난화 문제 해결을 위한 핵심 에너지원으로 떠오른 재생에너지. 하지만 풍력, 태양광 등 자연 에너지에 의존하는 발전 방식은 일정한 출력 유지가 어려워 에너지 저장 기술의 중요성이 강조되고 있다.최근 핀란드 에너지 저장 스타트업 '폴라나이트에너지(Polar Night Energy)'는 이러한...
망막박리, 백내장 등 시력 저하와 손실을 유발하는 요인은 여러 가지가 있을 수 있다. 유니버시티 칼리지 런던(University College London)의 안과 의사 리차드 리(Richard Lee) 박사 연구팀은 특정 유전성 안과 질환으로 인한 시력 저하가 장내 세균에 의해 유발될 수 있다는 사실을 밝혀냈다.이 연구 결과(논문명: CRB1-associated retinal degeneration is dependent on bacterial...
워싱턴대학 의대 연구팀이 수면 중 뇌에서 뉴런 활동이 리듬 파동을 만들어 뇌척수액을 움직여 노폐물을 제거하는 메커니즘을 밝혀냈다. 앞으로 알츠하이머병 등 신경퇴행성 질환 예방에 도움 될 수 있을 것으로 기대된다.이번 연구 결과(논문명: Neuronal dynamics direct cerebrospinal fluid perfusion and brain clearance)는 네이처(Nature) 지에 2월 28일(현지시각) 실렸다. 뇌세포는 생각과 감정, 신체 움직임을...
대장암은 일반적으로 40~50대 이상의 중장년층에서 많이 발생하는 암이지만, 그 이하의 젊은 연령층에서 대장암이 발생하지 않는 것은 아니다. 대장암 검진을 받는 비율이 낮은 젊은 연령층에서는 조기 발견이 어렵다는 것이 문제다. 새로운 연구에 따르면 50세 미만과 50세 이상 대장암 환자의 종양 내 장내 세균이 다르다는 사실이 밝혀졌다. 이는 젊은 층 대장암의 조기...
주의력결핍 과잉행동장애(ADHD 또는 ADD) 환자가 운동하면 체내 신경전달물질인 도파민과 노르아드레날린의 양이 증가하는 것으로 알려져 있다. 도파민과 노르아드레날린의 증가는 ADHD 증상 완화에 도움이 되는 것으로 알려져 있다. 충동성, 과잉행동, 부주의 등이 증상으로 나타나는 ADHD는 일반적으로 심리치료와 약물치료로 치료한다. 하지만 규칙적인 운동은 특정 뇌 영역에서 새로운 수용체의 성장을 촉진하여 체내 도파민과 노르아드레날린의...
기억력과 인지능력이 저하되는 알츠하이머병은 유전자, 환경, 생활습관 등이 원인이 되어 발병하는 것으로 알려져 있다. 그런데 2024년 1월 29일(현지시각) 학술지 네이처 메디신(Nature Medicine)에 게재된 논문(Iatrogenic Alzheimer’s disease in recipients of cadaveric pituitary-derived growth hormone)에서 '시체에서 추출한 성장호르몬을 투여하는 의료 시술로 인해 알츠하이머병이 전염됐을 가능성이 있는 사례'가 새롭게 보고됐다.뇌에서 발생하는 신경퇴행성 질환인...
반려동물이 주인을 행복하게 하는 것은 아니라는 연구 결과가 나왔다. 과거 연구에서는 반려견을 기르는 것이 주인의 정신적 안정과 고통 완화에 도움이 되는 것으로 알려졌다. 하지만 미시간주립대 최근 연구 결과에 따르면 반려동물이 행복도 측면에서 보면 인간을 그다지 행복하게 해주지 않을 수 있다는 것이다.연구 결과(논문명: The Perks of Pet Ownership? The Effects...
암흑물질의 기원은 물질이 형성되지 않은 또 다른 세계 '암흑 거울 우주(dark mirror' universe)라는 이론이 발표됐다. 즉 우리 우주 안에 원자가 형성되지 못한 '암흑 거울' 우주가 있을 수 있다는 새로운 연구 결과다.은하계 형성 등 우주의 존재 방식에 큰 영향을 미치지만 다른 물질과 상호작용하지 않고 눈에 보이지도 않는 암흑물질은 그 정체에...
실리콘을 이용해 에너지 밀도를 40% 향상하는 배터리 기술이 포항공대 연구팀에 의해 개발됐다. 연구팀은 배터리 기술 혁신을 통해 '1회 충전으로 1000km 주행이 가능한 전기차'의 실현을 목표로 하고 있다.연구 결과(논문명: Formulating Electron Beam-Induced Covalent Linkages for Stable and High-Energy-Density Silicon Microparticle Anode)는 국제학술지 어드밴스드 사이언스(Advanced Science)에 1월 17일 실렸다.일반에 판매되고 있는...
일상적인 운동은 몸과 마음에 다양한 이점을 가져다주는 것으로 알려져 있는데, 1만 명이 넘는 피험자의 뇌를 핵자기공명영상(MRI) 스캔으로 조사한 새로운 연구에 따르면, 걷기와 같은 신체 활동을 규칙적으로 하는 사람들은 중요한 영역의 뇌 부피가 더 큰 것으로 나타났다.미국 세인트루이스 워싱턴대학과 태평양 신경과학연구소 뇌건강센터(PBHC) 연구팀은 1,125명의 뇌 MRI 스캔 데이터를 분석한 결과,...


























![[보고서] 딥씨크 출현과 한국 AI 미래전략](http://8www.itnews.or.kr/wp-content/uploads/2025/02/7-218x150.png)

![[2024 애플 동향] ③ 애플카 ‘프로젝트 타이탄’의 실패 원인](http://8www.itnews.or.kr/wp-content/uploads/2024/03/1-2-218x150.png)
![[2024 애플 동향] ② 애플카 ‘프로젝트 타이탄’ 10년간 의 여정](http://8www.itnews.or.kr/wp-content/uploads/2024/03/4-218x150.png)
![[2024 애플 동향] ① 애플 프로젝트 타이탄’ 종료](http://8www.itnews.or.kr/wp-content/uploads/2024/03/Midjourney-218x150.png)